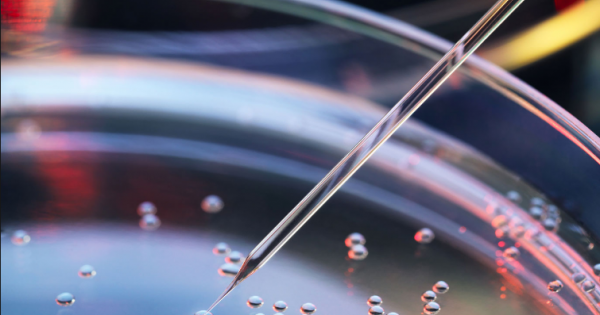
Células-tronco ajudam a recuperar área cerebral danificada por AVC

Células-tronco ajudam a recuperar área cerebral danificada por AVC
Exame | 30/01/2019
.png) Pesquisadores conseguiram diminuir lesões provocadas por isquemia cerebral no cérebro de camundongos usando .
Pesquisadores conseguiram diminuir lesões provocadas por isquemia cerebral no cérebro de camundongos usando .
Extraídas da medula óssea dos animais, as células-tronco mesenquimais – que originam tecidos – estavam em um suporte feito de um material que não só permitiu a sobrevivência e a multiplicação delas como impediu que migrassem para outras regiões do cérebro, como é comum ocorrer quando implantadas diretamente na lesão.
A técnica pode ajudar na recuperação de vítimas de acidente vascular cerebral (AVC) isquêmico, quando uma veia do cérebro é bloqueada (trombo) e a parte do cérebro que deixa de ser irrigada tem morte de neurônios. A isquemia pode causar sequelas graves, como perda de movimentos, e mesmo levar à morte.
Atualmente, há dois procedimentos possíveis para os pacientes que sofrem um AVC isquêmico. Um deles é a terapia de recanalização intravascular (trombólise), em que é aplicado um medicamento ativador de plasminogênio (rtPA) que desfaz o trombo. A outra opção é um cateterismo para desobstruir mecanicamente o vaso, para o sangue então voltar a circular.
No entanto, as terapias só têm eficácia se aplicadas em até quatro horas e meia após o AVC. Depois disso, a morte celular é irreversível. A nova técnica surge como uma possibilidade de tratamento mesmo depois desse intervalo.
Resultados do estudo foram publicados na Nanomedicine: Nanotechnology, Biology, and Medicine, em artigo que tem como primeira autora Laura Zamproni e é parte de seu doutorado com Bolsa da FAPESP na Escola Paulista de Medicina da Universidade Federal de São Paulo (EPM-Unifesp), onde atualmente faz pós-doutorado.
Zamproni é médica neurologista do Hospital São Paulo, da Unifesp. O trabalho no dia a dia despertou sua curiosidade para a pesquisa básica. “O procedimento que existe hoje para isquemia tem benefícios, mas mesmo quando realizado dentro desse curto intervalo ainda pode deixar sequelas e algum déficit cognitivo”, disse.
Não é a primeira vez que cientistas tentam usar células-tronco para recuperar uma área danificada do cérebro de camundongos ou ratos. Nos ensaios anteriores, porém, quando implantadas diretamente na lesão, quase nenhuma célula sobreviveu (0,005%). As que sobreviveram migraram para outras regiões do cérebro. Quando injetadas na corrente sanguínea, ficaram retidas nos rins ou nos pulmões das cobaias.
O que fez a diferença desta vez foi o uso de um material que, além de ser biocompatível (não tóxico), aumenta a sobrevivência das células-tronco e faz com que elas permaneçam na área da lesão, diminuindo a inflamação. Depois de alguns meses, com a área em grande parte recuperada, o material é totalmente absorvido pelo corpo.
A novidade foi desenvolvida pelos engenheiros biomédicos Anderson de Oliveira Lobo e Fernanda Roberta Marciano, da Universidade Brasil. Ambos tiveram auxílio Jovem Pesquisador da FAPESP.
A fibra que desenvolveram é de um polímero orgânico, o ácido polilático. Ela se forma quando colocada em um equipamento que aquece o material e gira em alta velocidade, como uma máquina de algodão-doce. O “algodão” que se forma tem fibras altamente porosas.
Para o estudo, as células-tronco mesenquimais foram retiradas da medula óssea de camundongos e cultivadas em placa de Petri. Em seguida foram depositadas no material.
“Quando esse material contendo as células-tronco mesenquimais foi implantado em um cérebro lesionado, a lesão ficou com um terço do tamanho que ficaria se não houvesse intervenção”, disse Marimélia Porcionatto, professora da EPM-Unifesp e coordenadora do estudo.
“Antes, realizamos vários testes para mostrar que as células não perdem características biológicas, como diferenciação e proliferação. Isso é importante, pois não podemos usar como suporte um material que altere muito as características da célula”, disse Porcionatto.
As fibras contendo as células-tronco foram então colocadas sobre a lesão e acompanhadas por 30 dias. Os pesquisadores observaram que elas se dão melhor no material do que na lamínula em que são normalmente cultivadas em laboratório.
Testes mostraram que elas produzem mais uma citocina chamada CXCL12, que atrai as células para a região. Além disso, produzem mais proteínas chamadas integrinas, que fazem as células-tronco aderirem à área em que estão.
“É como se a célula-tronco mesenquimal estivesse produzindo um ambiente apropriado para ficar. Ainda não sabemos o que nesse material causa isso, mas é muito interessante ver como um material não biológico interfere no comportamento da célula”, disse Porcionatto.
Os pesquisadores agora pretendem testar a técnica com células-tronco em traumatismo crânio-encefálico, em que há perda de parte do cérebro.
“Hoje, quando se perde massa encefálica, controla-se a hemorragia e se faz uma cirurgia, mas o que perdeu está perdido. Não tem como melhorar. Esse poderia ser um novo tratamento”, disse Zamproni.
Para isso, os pesquisadores querem usar bioimpressão, recriando a parte perdida do cérebro no mesmo formato com uma impressora 3D. Para isso, buscam encontrar outro biomaterial que possa também ser moldado, além de ter as propriedades do ácido polilático.